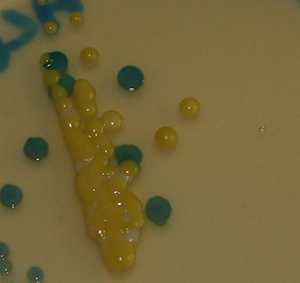

Werking selectieve voedingsbodems
Selectieve middelen:(waardoor gezochte bacterie wel groeit en de rest niet)
Electieve stoffen/reacties (waardoor gezochte bacterie te herkennen tussen andere bacterien)
- Zuurvorming uit koolhydraat
- Basevorming uit aminozuur
- Esculinesplitsing
- Telluriet
- Sulfiet
- Eidooier
- Chromogeen substraat
Hieronder een verdere bespreking:
Eerst de selectieve middelen:
Anorganische stoffen:
Natriumazide
Wordt gebruikt om gramnegatieve bacteriën in de groei te remmen (conc 0,02%). Het is een stof die de energiestofwisseling van de bacterie verstoort. Het wordt veel gebruikt in selectieve media voor Streptococcen.
Bismuth sulfiet
Een stof die in combinatie met briljantgroen bijna alle micro-organismen remt met uitzondering van de Salmonella-soorten. Omdat de stof erg instabiel is moet het medium steeds vers gemaakt worden.
Lithium(chloride)
Een metaal dat gramnegatieve organismen in de groei remt
Telluriet
Giftig voor gramnegatieve bacteriën maar ook voor veel grampositieve micro-organismen. Eidooier beschermt staphylococcen tegen de giftige werking.
Tetrathionaat: deze stof is giftig voor micro-organismen die niet in het bezit zijn van het enzym tetrathionase. Salmonella bezit dit enzym wel en is dus ongevoelig voor deze stof (mits de concentratie niet te hoog is, hoe hoger de incubatietemperatuur, hoe gevoeliger ook Salmonella wordt).
Hoge concentraties zout remmen de meeste micro-organismen maar niet de Staphylococcen.
Kleurstoffen
Acriflavine
Wordt veel gebruikt om Listeria op te hopen en te isoleren.
Briljantgroen
Remt de meeste grampositieve en sommige gram-negatieve bacteriën
Malachietgroen
Remt de meeste grampositieve en sommige gram-negatieve bacteriën
Kristalviolet
Remt de meeste grampositieve en sommige gram-negatieve bacteriën
Oppervlakactieve stoffen
Galpreparaten
Worden gewonnen uit de galblazen van slachtdieren. Het is een chemisch ongedefinieerd preparaat, zodat variaties tussen verschillende charges van een medium kunnen optreden. Media met extracten van natuurproducten dienen dan ook altijd door de fabrikant op hun werking getest te worden.
De galzouten werken tegen de meeste grampositieve bacteriën en sommige gramnegatieve bacteriën.
Desoxycholaat
Een specifiek galzout waarvan bekend is dat het het in hoge concentraties remmend werkt op grampositieve bacteriën en coliformen en niet op Salmonella, in lagere concentraties kunnen alle entero's goed groeien en de grampositieve bacterien niet. Citraat versterkt het remmend effect van desoxycholaat door de binding van Mg wat de remmende werking van desoxycholaat verzwakt.
Cetrimide
Heeft een breed werkingsspectrum, het werkt in op de membranen van vrijwel alle micro-organismen behalve Pseudomonas.
Laurylsulfaat
Gaat de groei van grampositieve micro-organismen tegen.
Antibiotica
Antibiotica zijn antimicrobe stoffen gevormd door micro-organismen. Ze werken specifiek, dus tegen bepaalde groepen micro-organismen. In veel gevallen voegt men een mengsel van twee of drie antibiotica aan een selectief medium toe. Dit gebeurt vrijwel altijd na sterilisatie, omdat de meeste antibiotica hittelabiel zijn.
Bekende voorbeelden zijn:
Polymyxine-B-Sulfaat in selectieve media voor Bacillus cereus
Oxytetracycline in media voor de isolatie en teling van schimmels en gisten
Natamycine om schimmels en gisten in de groei te remmen
"Moeilijke energiebron"
Behalve dat men een remstof kan toevoegen aan een medium om het selectief te maken is het ook mogelijk om een gemakkelijke energiebron weg te laten en te vervangen door een energiebron die maar weinig micro-organismen kunnen gebruiken. Tot deze laatste groep behoren dan uiteraard de micro-organismen die men wil bepalen.
Een bekend voorbeeld is lactose en de coliformen waaronder Escherichia coli , E.coli. Omdat lactose alleen door de coliforme enterobacteriën wordt vergist en niet door de hele groep kan men met deze stof als energiebron de coliformen bevoordelen, daarnaast kan men deze vergisting zichtbaar maken door op gasvorming te letten of door de zuurvorming aan te tonen.
Electieve ingrediënten
Om een bepaalde bacterie te herkennen uit een grotere groep welke op een selectief medium kan groeien is het buitengewoon handig om het medium ook electief te maken. Het kan zijn dat alleen de gezochte bacterie een betekenis heeft voor de kwaliteit van het product en/of de veiligheid voor de consument. Het selectieve medium laat dan eigenlijk "te veel " micro-organismen groeien zodat de electieve stoffen de beslissing moeten brengen of men al dan niet met de boosdoener te maken heeft. Hieronder volgen een aantal voorbeelden van electieve eigenschappen waarmee het mogelijk is specifieke bacteriën te herkennen.
De vorming van zuur of gas uit een suiker
Zoals bij moeilijke energiebron al staat vermeld kan men aan een medium een bepaalde energiebron (suiker) toevoegen en vervolgens nagaan of deze wordt vergist. Deze vergisting kan men zichtbaar maken door een pH-indicator aan het medium toe te voegen welke de verzuring zichtbaar maakt. Alleen rond de zuurvormende kolonies vindt dan een verkleuring plaats.
Gasvorming is te zien als opstijgende belletjes (prik), of met behulp van een Durhambuisje waarin het gas opgevangen wordt.
De vorming van basische stoffen uit aminozuren
Als er voor hem geen vergistbaar suiker in de buurt is zal een micro-organisme zich moeten redden met pepton als energiebron. Zo'n micro-organisme vormt hieruit dan basische stoffen welke ook zichtbaar gemaakt kunnen worden met een pH-indicator, zo kan het zijn dat men een en dezelfde plaat zowel zuurvormende als basevormende soorten kan herkennen (om ze eventueel daarna verder te onderzoeken).
Esculinesplitsing
Kan een bacterie zoals een streptococ esculine splitsen dan onstaat een zwart gekleurde stof en dus ook een zwarte kolonie.
Tellurietomzetting
Kan een bacterie telluriet omzetten tot het zwarte telluur dan vormen zich zwarte kolonies.
Vorming van waterstofsulfide uit sulfiet
Kan een bacterie uit sulfiet sulfide vormen dan onstaat er met Ijzer(ionen) welke dus ook in het medium moeten zitten een zwart neerslag
Reacties met eidooier
Door het toevoegen van een eidooieremulsie wordt het medium geel en ondoorschijnend. Met deze eidooier zijn verschillende reacties mogelijk, sommige micro-organismen zijn in staat om door proteolyse (eiwitsplitsing) een helder zone te vormen rond hun kolonie. Daarnaast zijn er micro-organismen welke juist een brede neerslagzone vormen door het het lecithine dat in eidooier zit af te breken. Ook zijn er nog micro-organismen welke m.b.v. lipase aanwezige vetten splitsen waarbij vetzuren neerslaan, hierbij ontstaat een kleine neerslagring van vetzuren.

Bacillus cereus op selectieve en tegelijkertijd electieve agar. (Bacillus cereus selective agar van Oxoid).
Bacillus cereus is herkenbaar door een neerslagzone rondom de groei en verkleurt de voedingsbodem blauw.
Voor de selectiviteit is polymyxine toegevoed.
Chromogene substraten
Het meest specifiek werken media waarin zich een zogenaamd chromogeen of fluorogeen substraat bevindt.
Dit zijn stoffen die door een (uiteraard specifiek) enzym kunnen worden omgezet in een gekleurde of fluorescerende verbinding. Omdat het bezit van het enzym dat het substraat kan omzetten soort- of groepsspecifiek is kan men op een plaat een bepaalde soort of groep onderscheiden van de andere micro-organismen. Als men dan per substraat nog een andere kleur kiest kunnen op een medium verschillende groepen micro-organismen herkend worden.
Zo kunnen op een selectieve plaat voor coliformen de coliformen herkend worden aan hun rode kleur het resultaat van de vorming van een enzym welke van een bepaald substraat een rode kleur afsplitst wordt terwijl Escherichia coli dankzij nog een extra soortspecifiek enzym donkerblauw tot paars wordt.
Ook is er (s)electieve voedingsbodem voor Listeria met het chromogeen X-glucoside dat door Listeria soorten wordt gesplitst met het enzym ß-glucosidase waarbij een blauwe kleurstof wordt gevormd. Andere micro-organismen met dit enzym worden door selectieve stoffen (lithium chloride, polymyxine B en nalidixinezuur) in hun groei geremd.
Meer info:
Voedingsbodems voor :
Bacillus cereus, Enterobacterien, Salmonella
kwaliteitscontrole van selectieve voedingsbodems




